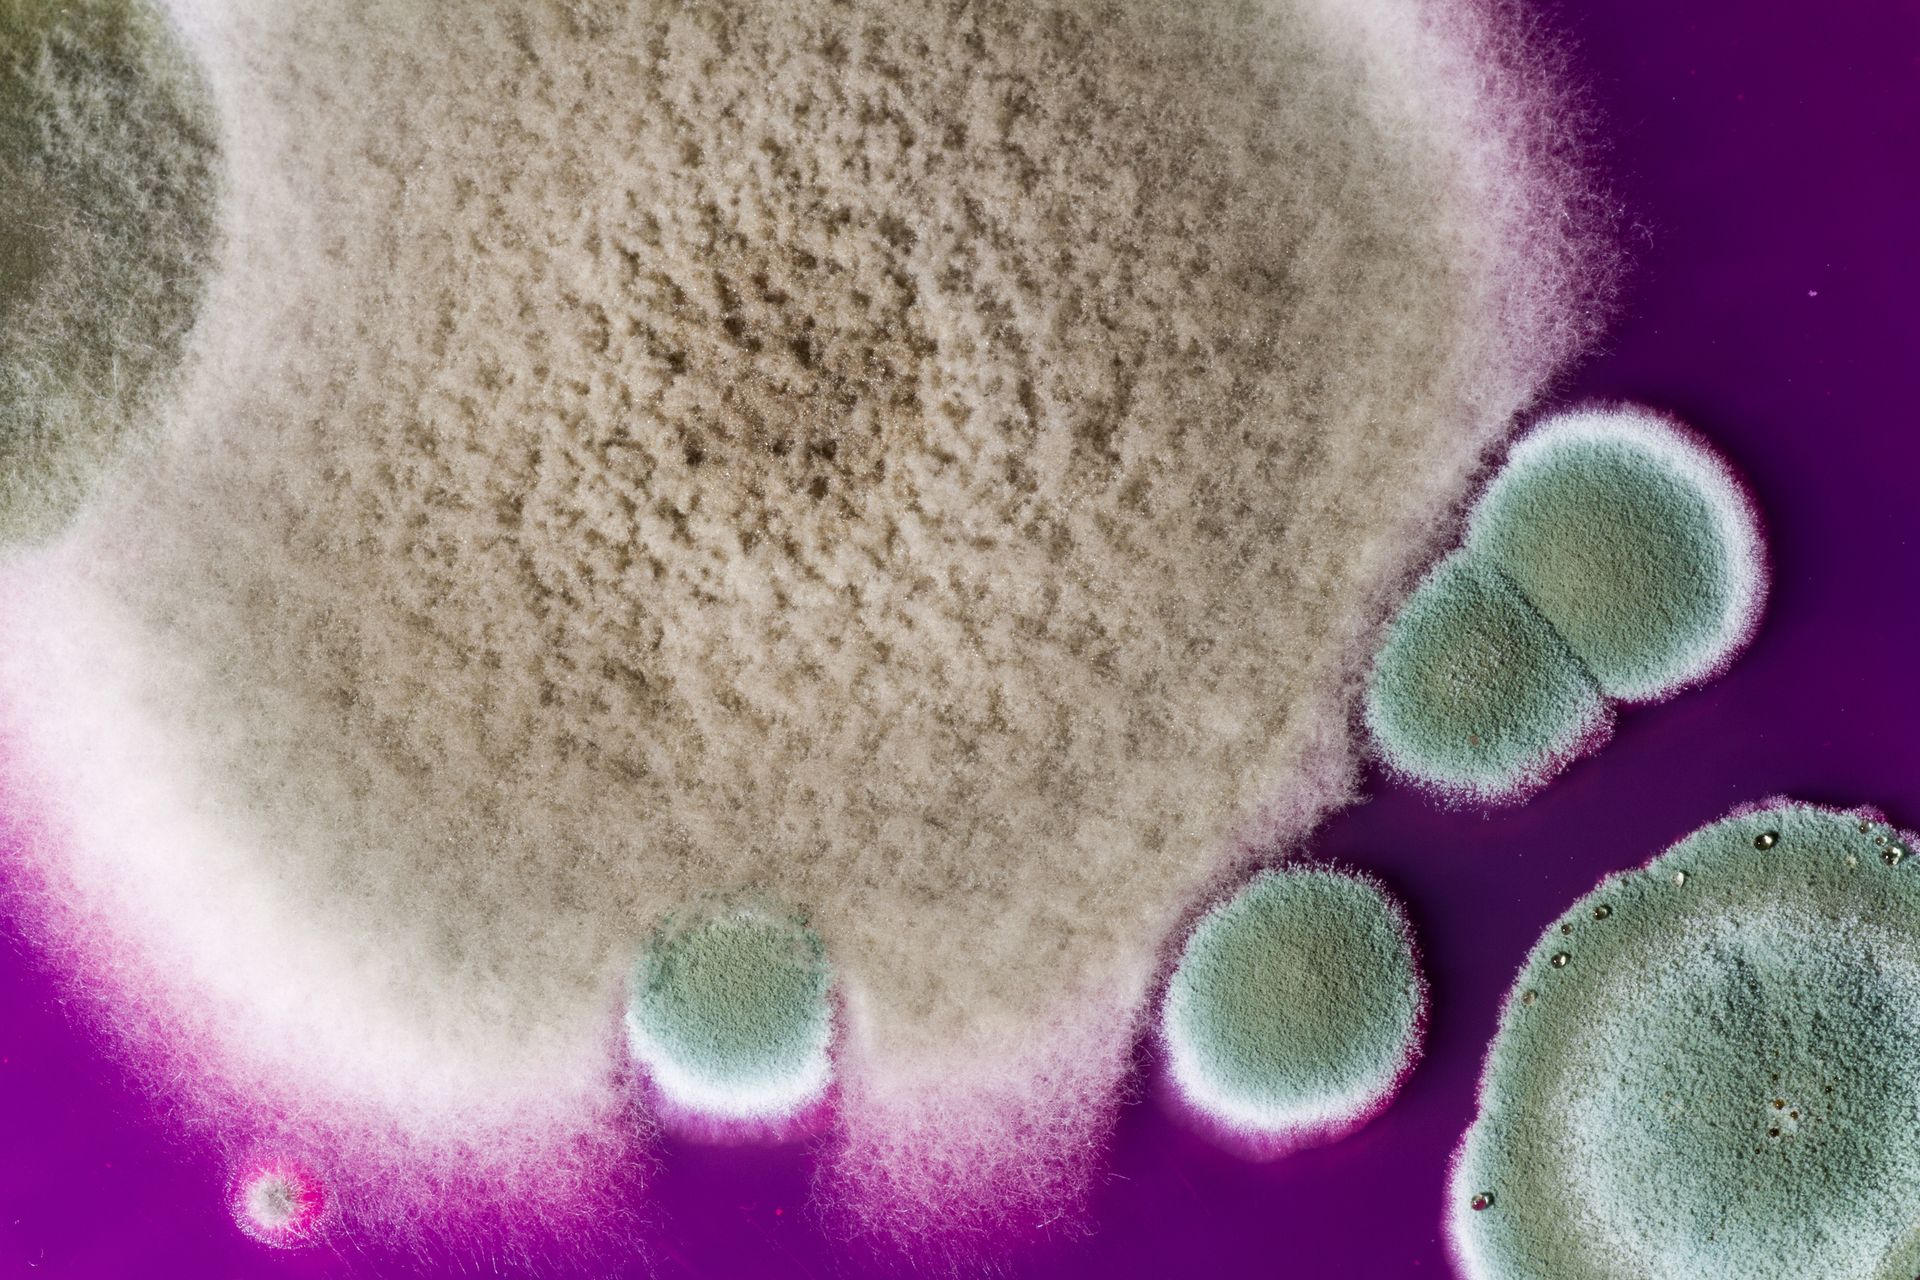
Colonies of mold with varying textures and colors, growing on a purple surface.

Asbestos and Mold Inspection Services in Brook Park, Ohio
RTS Environmental Inspections, a licensed asbestos building inspector and licensed in asbestos management planning, provides certified asbestos and mold inspection services in Brook Park, Ohio. We help residential, commercial, construction, and industrial clients maintain safe and compliant properties. Our services meet strict state and federal regulations, including 40 CFR Subpart 763.85–763.99. Whether you need full asbestos surveys, mold air sampling, or environmental management planning, our experienced team delivers reliable results you can trust. Call us today at
(216) 423-3850
to schedule your inspection in Brook Park, Ohio.
Fully Compliant Environmental Inspection Services
Environmental safety is not optional—it is required by law and essential for protecting occupants. Our services are fully compliant with federal asbestos regulations under 40 CFR Subpart 763.85–763.99. We follow established protocols for inspection, sampling, documentation, and reporting to ensure every project meets regulatory standards.
We work closely with property owners, facility managers, contractors, and homeowners to provide thorough assessments that reduce liability and promote health and safety. Every inspection is conducted with precision, professionalism, and attention to detail.


Professional Asbestos Inspections and Full Surveys
Asbestos-containing materials can pose serious health risks when disturbed. Our asbestos services include comprehensive inspections and sampling for residential, commercial, construction, and industrial properties.
We perform:
- Full asbestos surveys.
- Targeted asbestos inspections.
- Material sampling.
- Laboratory analysis coordination.
All collected samples are sent to certified laboratories for detailed analysis. Once results are received, we provide clear documentation outlining findings and recommendations. Whether you are planning renovations, demolition, property transactions, or compliance updates, our asbestos surveys help you move forward confidently and legally.
Mold Inspections and Air Sampling Services
Mold growth can lead to structural damage and potential health concerns if left unaddressed. Our mold inspection services are designed to identify visible and hidden mold issues quickly and accurately.
Our mold services include:
- Visual mold inspections.
- Surface sampling.
- Air sampling.
- Laboratory analysis coordination.
We collect samples using professional-grade equipment and send them to certified laboratories for analysis. Once results are available, we provide a detailed report explaining the findings and outlining recommended next steps.
Whether you suspect moisture damage in a home, office, or industrial facility, we provide reliable testing to help you make informed decisions.


Asbestos Management Planning
Asbestos Management Planning
In addition to inspections and testing, RTS Environmental Inspection provides asbestos management planning services. Management plans are essential for maintaining compliance in facilities where asbestos-containing materials are present but not immediately removed.
Our management planning services include:
- Identification of asbestos-containing materials.
- Risk assessment documentation.
- Monitoring recommendations.
- Regulatory compliance documentation.
We help property owners and facility managers maintain compliance while ensuring occupant safety. Our plans are designed to align with state and federal standards, providing clarity and long-term protection.
Serving Residential, Commercial, Construction, and Industrial Clients
We proudly serve a wide range of industries throughout Brook Park, Ohio, and surrounding communities. Our clients include:
- Residential homeowners.
- Commercial property owners.
- Construction companies.
- Industrial facilities.
Each industry has unique compliance and safety requirements. We tailor our inspection and reporting process to meet the specific needs of your project, whether it involves pre-renovation surveys, post-construction evaluations, or ongoing facility management.
Why Choose RTS Environmental Inspections?
Choosing the right environmental inspection company matters. Our team is committed to accuracy, compliance, and dependable service. We prioritize clear communication, timely reporting, and strict adherence to regulatory guidelines.
When you work with us, you can expect:
Thorough and professional inspections.
Certified laboratory analysis.
Regulatory compliance expertise.
Clear, detailed documentation.
Responsive customer service.
We understand the importance of environmental safety and regulatory compliance. Our mission is to provide dependable inspection services that protect people, properties, and businesses.
Schedule Your Environmental Inspection Today
If you need asbestos inspections, mold testing, full asbestos surveys, or management planning in Brook Park, Ohio, RTS Environmental Inspection is ready to assist. We are committed to delivering accurate results and compliant services that give you peace of mind.
Call
(216) 423-3850 today to schedule your asbestos or mold inspection and take the first step toward a safer, compliant property.
